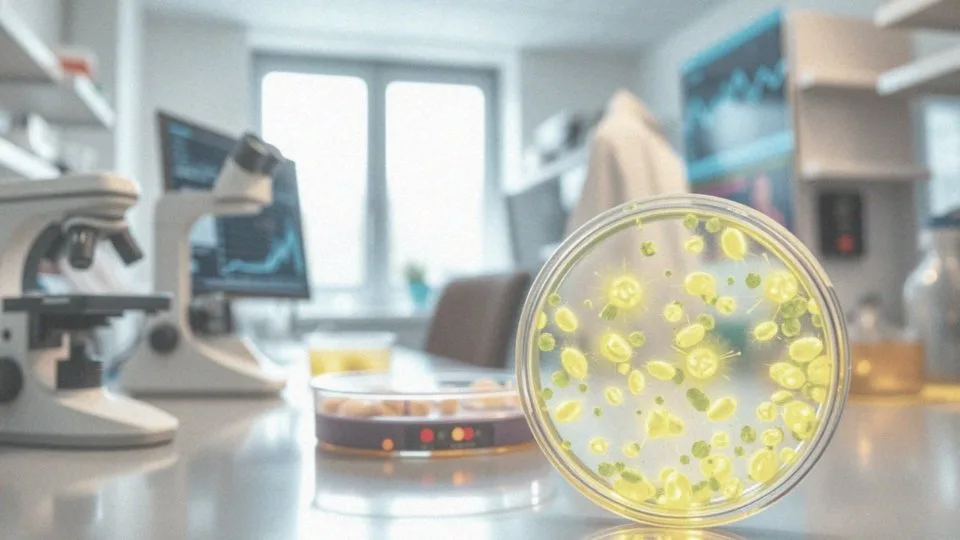
W jaki sposób terapia mitochondrialna może wspierać zdrowie psychiczne?

Spis treści
Co to jest terapia mitochondrialna?
Terapia mitochondrialna to innowacyjna metoda zdrowotna, która koncentruje się na efektywnym działaniu mitochondriów – kluczowych elementów odpowiedzialnych za wytwarzanie energii w naszym ciele. Łączy wiedzę naukową z praktykami medycznymi w celu optymalizacji ich funkcjonowania, co jest niezwykle istotne, zwłaszcza w kontekście wielu schorzeń powiązanych z ich dysfunkcją. Głównym zamierzeniem tej terapii jest zwiększenie poziomu energii u pacjentów.
W terapii mitochondrialnej skupiono się na kilku kluczowych aspektach, które obejmują:
- odpowiednią suplementację,
- zdrową dietę,
- techniki relaksacyjne, które pomagają w redukcji stresu.
Takie zintegrowane podejście sprzyja całościowemu wsparciu organizmu na poziomie komórkowym. Dzięki niemu wiele osób może zauważyć znaczną poprawę jakości życia.
Jakie są główne filary terapii mitochondrialnej?
Terapia mitochondrialna opiera się na pięciu fundamentalnych obszarach, które mają na celu wspieranie zdrowia mitochondriów oraz ich funkcji energetycznych:
- właściwe odżywianie,
- umiarkowana aktywność fizyczna,
- redukcja stresu,
- jakość snu,
- uzupełnianie mikroskładników odżywczych.
Pierwszym z nich jest właściwe odżywianie. Dieta bogata w mikroelementy, takie jak witaminy z grupy B, koenzym Q10 i różne antyoksydanty, zapewnia niezbędne substancje do produkcji energii. Drugim istotnym aspektem jest umiarkowana aktywność fizyczna. Regularne ćwiczenia, jak jogging czy pływanie, zwiększają efektywność mitochondriów, co przekłada się na ich większą liczbę i lepszą wydolność. Kolejnym ważnym elementem jest redukcja stresu, ponieważ wysoki poziom kortyzolu może negatywnie wpływać na mitochondria. Dlatego techniki relaksacyjne, takie jak medytacja czy głębokie oddychanie, mogą okazać się niezmiernie skuteczne w radzeniu sobie z napięciem. Czwartym filarem jest jakość snu; odpowiednia ilość oraz jakość snu są kluczowe dla regeneracji mitochondriów i optymalizacji ich metabolizmu. Ostatni filar odnosi się do uzupełniania mikroskładników odżywczych. Odpowiednie suplementy mogą efektywnie wspierać produkcję energii oraz poprawiać funkcjonowanie mitochondriów. Połączenie tych wszystkich elementów w zdrowy styl życia znacząco wpływa na poprawę samopoczucia i ogólnej jakości życia.
Czym charakteryzuje się kompleksowa terapia mitochondrialna?
Kompleksowa terapia mitochondrialna to holistyczne podejście, które łączy nowoczesne badania naukowe z indywidualnym podejściem do pacjenta. Proces ten uwzględnia różnorodne aspekty zdrowia, takie jak:
- diety sprzyjające prawidłowemu funkcjonowaniu mitochondriów,
- odpowiednia suplementacja niezbędnych mikroskładników,
- techniki redukcji stresu,
- wsparcie autonomicznego układu nerwowego.
To, co odróżnia ten program od bardziej tradycyjnych metod leczenia, to skupienie się na identyfikacji i eliminacji przyczyn zaburzeń mitochondrialnych, zamiast jedynie łagodzenia objawów. Kluczowym elementem tego podejścia jest dostosowanie planu terapeutycznego do specyficznych potrzeb pacjenta. Dzięki temu można wprowadzić:
- dieta bogata w antyoksydanty, takie jak witaminy A, C, E,
- mikroelementy, na przykład koenzym Q10.
To wszystko znacząco zwiększa wydajność mitochondriów. Dodatkowo, poprawa jakości snu oraz regularna, zrównoważona aktywność fizyczna sprzyjają regeneracji organizmu i produkcji energii na poziomie komórkowym. Integracja technik relaksacyjnych, takich jak medytacja, pomaga w regulacji układu nerwowego, co korzystnie wpływa na zdrowie psychiczne pacjentów oraz ich ogólne samopoczucie. To kompleksowe podejście przyczynia się do widocznej poprawy jakości życia osób z zaburzeniami mitochondrialnymi i innymi problemami zdrowotnymi.
Jak terapia mitochondrialna wspiera pracę mitochondriów?
Terapia mitochondrialna odgrywa istotną rolę w wspieraniu funkcji mitochondriów, oferując wiele korzyści. Kluczowym aspektem jest odpowiednia suplementacja, która dostarcza organizmowi niezbędne składniki odżywcze. Mitochondria pełnią kluczową rolę w produkcji energii w formie ATP. Aby zwiększyć ich wydajność, warto wzbogacić codzienne menu o:
- witaminy z grupy B,
- koenzym Q10,
- antyoksydanty, takie jak witamina C i E.
Co więcej, ta terapia skutecznie redukuje stres oksydacyjny, który negatywnie wpływa na mitochondria. Techniki medytacji i oddechu mogą dodatkowo wspierać ochronę neuronów, co korzystnie wpływa na ich funkcjonowanie. Zrównoważona dieta oraz odpowiednio dobrane suplementy przynoszą nie tylko korzyści w postaci wzmożonej produkcji energii, ale także sprzyjają regeneracji mitochondriów. Dodatkowo, terapia mitochondrialna przyczynia się do zmniejszenia stanów zapalnych w organizmie, co znacząco wspiera zdrową pracę mitochondriów. Jak widać, dzięki tym różnorodnym działaniom, terapia staje się skutecznym narzędziem, które może poprawić jakość życia oraz stan zdrowia pacjentów.
Jak mikroskładniki odżywcze wspierają pracę mitochondriów?
Mikroskładniki odżywcze, takie jak:
- witaminy,
- minerały,
- koenzym Q10,
- flawonoidy,
- przeciwutleniacze,
odgrywają kluczową rolę w prawidłowym funkcjonowaniu mitochondriów, które są odpowiedzialne za produkcję energii w formie ATP. Odpowiedni poziom tych składników wpływa na wydajność mitochondriów oraz ich zdolność do regeneracji. Szczególnie koenzym Q10 ma ogromne znaczenie, gdyż uczestniczy w łańcuchu oddechowym mitochondriów, co sprawia, że proces energetyczny jest bardziej efektywny. Flawonoidy, obecne w wielu owocach i warzywach, działają jako silne przeciwutleniacze, które chronią mitochondria przed uszkodzeniami spowodowanymi stresem oksydacyjnym. Witaminy z grupy B, takie jak B1, B2, B3, B5, B6 i B12, są niezbędne do efektywnego przetwarzania energii z pokarmów, a ich niedobór może prowadzić do osłabienia wydolności mitochondrialnej. Ponadto minerały, takie jak magnez i cynk, wspierają zdrowie mitochondriów, biorąc udział w licznych procesach enzymatycznych, które są niezbędne do ich prawidłowego działania.
Regularne dostarczanie tych mikroskładników nie tylko wspomaga produkcję ATP, ale również redukuje stany zapalne, które mogą negatywnie wpływać na mitochondria. Dlatego dbając o odpowiednią podaż tych składników, mamy szansę na znaczną poprawę naszego samopoczucia oraz efektywności procesów metabolicznych w organizmie.
Jak właściwe odżywianie wpływa na efektywność terapii mitochondrialnej?

Odpowiednia dieta odgrywa kluczową rolę w skuteczności terapii mitochondrialnej. Spożywanie produktów bogatych w witamin, minerały i zdrowe tłuszcze sprzyja prawidłowemu funkcjonowaniu mitochondriów, które odpowiadają za wytwarzanie energii w formie ATP. Właściwe proporcje tych składników są konieczne do maksymalizacji metabolizmu komórkowego. Liczni badacze podkreślają, że:
- rezygnacja z przetworzonej żywności,
- ograniczenie cukrów.
Te działania mogą znacznie obniżyć obciążenie metaboliczne i stres oksydacyjny, co ma pozytywny wpływ na mitochondria. Zbilansowana dieta, bogata w białko, zdrowe tłuszcze i błonnik, stabilizuje również poziom glukozy we krwi, co jest korzystne dla funkcji mitochondrialnych. Innym istotnym elementem są naturalne źródła antyoksydantów, takie jak owoce i warzywa, które pomagają w neutralizacji wolnych rodników, chroniąc w ten sposób komórki przed uszkodzeniami. Dla pacjentów uczestniczących w terapii mitochondrialnej, współpraca z dietetykiem klinicznym jest niezwykle wartościowa. Taki ekspert pomoże dostosować plan żywieniowy do specyficznych potrzeb, co może znacząco wpłynąć na efektywność terapii i poprawę ogólnego stanu zdrowia. Systematyczne dostarczanie niezbędnych mikroskładników oraz odpowiednia suplementacja mogą przyczynić się do zwiększenia efektów terapeutycznych, co z kolei zwiększa prawdopodobieństwo pozytywnych rezultatów w leczeniu schorzeń związanych z dysfunkcją mitochondriów.
Dlaczego redukcja stresu jest ważna dla terapii mitochondrialnej?
Redukcja stresu odgrywa kluczową rolę w skuteczności terapii mitochondrialnej. Długotrwały stres przyczynia się do wzrostu produkcji wolnych rodników, co ma negatywny wpływ na mitochondria i obniża ich zdolność do produkcji energii. Dlatego tak ważne jest, aby poprawić regulację autonomicznego układu nerwowego, korzystając z różnych technik łagodzenia stresu. Przykładowo:
- medytacja,
- joga,
- terapia oddechowa.
Te praktyki mogą pomóc w przywróceniu równowagi w organizmie, co korzystnie wpływa na zdrowie mitochondriów. Dzięki tym praktykom możliwe jest obniżenie poziomu kortyzolu, który ma destrukcyjny wpływ na mitochondrialne funkcje. Regularne stosowanie metod relaksacyjnych poprawia zmienność zatokową rytmu serca (HRV), co oznacza lepszą regulację układu nerwowego. Dbałość o redukcję stresu, poprzez odpowiedni sen i różne techniki relaksacyjne, wspiera regenerację mitochondriów oraz pozytywnie wpływa na samopoczucie pacjentów. Zwrócenie uwagi na te elementy jest zatem niezwykle istotne w kontekście terapii mitochondrialnej, gdyż może znacząco poprawić jakość życia osób z zaburzeniami mitochondrialnymi.
W jaki sposób zdrowy sen wpływa na regenerację mitochondriów?
Odpowiedni sen odgrywa kluczową rolę w regeneracji mitochondriów, odpowiedzialnych za wytwarzanie energii w ciele. Podczas snu nasze organizmy mają szansę na naprawę uszkodzeń komórkowych oraz optymalizację procesów metabolicznych. Jakość snu ma bezpośredni wpływ na produkcję melatoniny, naturalnego przeciwutleniacza, który zabezpiecza mitochondria przed stresem oksydacyjnym.
Osoby borykające się z problemami ze snem często doświadczają zaburzeń w funkcjonowaniu mitochondriów, co z kolei prowadzi do obniżonego poziomu energii oraz wzmożonego zmęczenia. Dobrze przespana noc wspomaga regenerację organizmu, co korzystnie oddziałuje na zdrowie mitochondriów.
Badania wykazują także, że niedobór snu zwiększa stan zapalny, co negatywnie wpływa na funkcjonowanie mitochondriów. Istotne są również cykle snu, a szczególnie faza REM, podczas której następuje intensywna regeneracja komórek.
Ustalona organizacja snu na poziomie 7-9 godzin dziennie przyczynia się do poprawy działania mitochondriów, efektywniej produkując ATP. Wdrożenie zdrowych nawyków związanych ze snem może znacząco poprawić jakość życia oraz wspierać terapie, takie jak terapia mitochondrialna, skupiająca się na zdrowiu na poziomie komórkowym.
Dlatego troska o jakość snu jest fundamentem zdrowego stylu życia, który sprzyja regeneracji mitochondriów i ogólnemu samopoczuciu.
Jakie schorzenia można leczyć dzięki terapii mitochondrialnej?
Terapia mitochondrialna zyskuje uznanie jako skuteczna metoda w walce z różnorodnymi schorzeniami, zwłaszcza tymi, które wynikają z zaburzeń funkcji mitochondriów. Istotne przypadki obejmują choroby neurologiczne, takie jak:
- autyzm,
- padaczka,
- choroba Parkinsona,
- Alzheimer.
Osoby borykające się z przewlekłym zmęczeniem, depresją czy stanami zapalnymi również mogą odnaleźć ulgę w tej formie leczenia. Wspieranie funkcji mitochondrialnych może przynieść istotne korzyści w terapii chorób neurodegeneracyjnych. Zwiększona produkcja energii odgrywa kluczową rolę w polepszaniu zarówno wydolności psychicznej, jak i fizycznej. Dowody naukowe sugerują, że właściwe działanie mitochondriów może przyczynić się do łagodzenia objawów tych dolegliwości.
Suplementy zawierające witamin B, koenzym Q10 oraz antyoksydanty efektywnie wspierają proces regeneracji organizmu. Dodatkowo, łączenie terapii mitochondrialnej z innymi metodami leczenia może prowadzić do znacznego wzmocnienia jej skuteczności. Dlatego nie dziwi fakt, że terapia mitochondrialna staje się coraz bardziej popularna w ramach holistycznego podejścia do zdrowia.
Jakie są zalety terapii mitochondrialnej w porównaniu do farmakoterapii?
Terapia mitochondrialna oferuje wiele korzyści w porównaniu do tradycyjnej farmakoterapii. Jej głównym atutem jest to, że stawia na leczenie źródła problemów zdrowotnych, zamiast jedynie łagodzić objawy.
Dzięki wspieraniu naturalnych procesów regeneracji organizmu, pacjenci mogą:
- zredukować konieczność stosowania leków,
- zmniejszyć ryzyko wystąpienia niepożądanych reakcji,
- poprawić ogólną jakość życia.
Ponadto terapia ta wspiera mitochondria, co przekłada się na wzrost energii oraz lepszą wydolność fizyczną. Oferuje wszechstronne podejście do zdrowia, które uwzględnia:
- dieta,
- suplementacja,
- techniki relaksacyjne,
- aktywny styl życia.
W przeciwieństwie do tradycyjnych leków, które często przynoszą jedynie chwilowe efekty, terapia mitochondrialna koncentruje się na długofalowym zdrowiu i trwałej poprawie jakości życia. Co więcej, połączenie tej terapii z farmakoterapią może prowadzić do synergicznych efektów leczniczych, wzmacniając skuteczność w przypadku chorób współistniejących, na przykład:
- autyzmu,
- innych zaburzeń neurologicznych.
W związku z tym terapia mitochondrialna jawi się jako obiecująca alternatywa lub uzupełnienie klasycznych metod leczenia, skupiając się na przywracaniu naturalnej harmonii w organizmie.
Jakie są korzyści zdrowotne z wprowadzenia terapii mitochondrialnej?
Terapia mitochondrialna przynosi szereg korzyści zdrowotnych, które zasługują na uwagę. Przede wszystkim, jej wpływ na poziom energii jest znaczący. Pacjenci często zauważają, że chroniczne zmęczenie oraz uczucie wyczerpania ustępują, co z kolei prowadzi do poprawy wydolności fizycznej i ogólnego samopoczucia.
Co więcej, terapia ta korzystnie oddziałuje na procesy poznawcze – wiele osób korzystających z niej deklaruje:
- lepszą koncentrację,
- większą pamięć.
Takie zmiany są efektem usprawnionej produkcji energii przez mitochondria, co wspiera działania neuroenergetyczne w mózgu. Nie można zapomnieć, że terapia ma również pozytywny wpływ na nastrój, co przekłada się na lepszą jakość życia oraz ułatwia nawiązywanie relacji społecznych. Dodatkowo, istotnym elementem działania terapii jest wzmocnienie układu odpornościowego. Dzięki redukcji stanów zapalnych oraz ochronie mitochondriów przed stresem oksydacyjnym, organizm zyskuje lepszą zdolność do obrony.
Również badania wskazują, że terapia wpływa pozytywnie na jakość snu, co sprzyja regeneracji ciała oraz poprawia funkcje metaboliczne. Holistyczne podejście, jakie prezentuje terapia mitochondrialna, łączy różnorodne metody wsparcia zdrowia, na co pacjenci mogą liczyć jako na kompleksowe rozwiązanie. Dzięki temu, stają się bardziej otwarci na długofalowe zdrowie oraz lepszą jakość codziennego życia.
W jaki sposób terapia mitochondrialna może wspierać zdrowie psychiczne?
Terapia mitochondrialna odgrywa istotną rolę w wspieraniu zdrowia psychicznego, angażując różnorodne mechanizmy. Na pierwszym planie stoi:
- poprawa funkcjonowania mózgu,
- równowaga neuroprzekaźników,
- wsparcie w leczeniu zaburzeń neurologicznych,
- regulacja autonomicznego układu nerwowego,
- redukcja stresu oksydacyjnego.
Mitochondria, jako kluczowe elementy odpowiedzialne za wytwarzanie energii, są fundamentem prawidłowego działania neuronów. Udoskonalenie ich pracy wpływa na bardziej efektywny metabolizm mózgu, co może przyczynić się do polepszenia nastroju oraz łagodzenia symptomów depresji i lęku. Techniki redukujące stres oksydacyjny, takie jak medytacja, znacząco wspierają zarówno funkcje poznawcze, jak i ogólny stan zdrowia.
Terapia mitochondrialna może być efektywną strategią w leczeniu zaburzeń neurologicznych, szczególnie w kontekście depresji czy autyzmu, gdyż stymuluje procesy regeneracji organizmu. Liczne badania potwierdzają jej skuteczność w poprawie zdrowia psychicznego u osób z różnymi wyzwaniami. Dodatkowo, przyjmowanie mikroskładników jak koenzym Q10 oraz witamin z grupy B wspiera optymalizację działania mitochondriów, co z kolei przekłada się na lepsze zdrowie psychiczne oraz wyższą jakość życia.
Jakie są najnowsze badania dotyczące terapii mitochondrialnej?

Najnowsze badania dotyczące terapii mitochondrialnej koncentrują się na jej potencjale w zwalczaniu chorób neurodegeneracyjnych, w tym:
- choroby Alzheimera,
- choroby Parkinsona,
- zaburzeń metabolicznych,
- autyzmu.
Okazuje się, że zdrowa dieta oraz odpowiednia suplementacja mają kluczowe znaczenie w wspieraniu funkcji mitochondrialnych. Innowacyjne metody, takie jak stymulacja nerwu błędnego (tVNS), mogą znacznie poprawić stan zdrowia pacjentów. Badania potwierdzają, że substancje odżywcze, w tym witaminy z grupy B oraz koenzym Q10, odgrywają ważną rolę w skuteczności tych terapii.
Oprócz tego, właściwe odżywianie i techniki obniżające stres są niezbędne do poprawy metabolizmu mitochondrialnego. Coraz więcej dowodów wskazuje, że holistyczne podejście, łączące zmiany dietetyczne z nowoczesnymi metodami terapeutycznymi, przynosi wyraźne korzyści dla jakości życia pacjentów. Dodatkowo, badania pokazują, że suplementacja oraz aktywność fizyczna wspomagają regenerację mitochondriów i redukują stany zapalne, co może łagodzić objawy wielu schorzeń.
Integracja terapii mitochondrialnej z konwencjonalnym leczeniem przynosi pozytywne rezultaty, oferując synergiczne działanie. Dlatego terapia mitochondrialna jawi się jako obiecująca strategia w walce z przewlekłymi dolegliwościami.
Co to jest suplementacja mitochondrialna i jak może pomóc?
Suplementacja mitochondrialna to fascynujący proces, który ma na celu wsparcie funkcjonowania mitochondriów poprzez wprowadzenie starannie dobranych dodatków do diety. Te maleńkie organelle odgrywają kluczową rolę w produkcji energii w formie ATP, co czyni je niezbędnymi dla naszego zdrowia. Warto zwrócić uwagę na suplementy, takie jak:
- koenzym Q10,
- flawonoidy,
- resweratrol,
- kwas alfa-liponowy,
- witaminy z grupy B,
które dostarczają cennych składników odżywczych, podnosząc efektywność mitochondriów. Jednym z głównych atutów suplementacji mitochondrialnej jest znaczne zwiększenie produkcji energii. Dowody naukowe sugerują, że koenzym Q10, często stosowany w terapii chorób serca, nie tylko wzmacnia działanie mitochondriów, ale także chroni je przed uszkodzeniami spowodowanymi stresem oksydacyjnym. Flawonoidy, naturalnie obecne w owocach i warzywach, pełnią funkcję silnych antyoksydantów, wspierając redukcję stanów zapalnych, które mogą negatywnie oddziaływać na kondycję mitochondriów. Suplementacja ma szczególne znaczenie, zwłaszcza w świetle faktu, że wiele osób może nie dostarczać wystarczającej ilości tych składników w codziennym jadłospisie. Dlatego tak istotne jest podejście indywidualne, oparte na badaniach oraz konsultacjach z ekspertami, które może znacznie wpłynąć na poprawę funkcjonowania mitochondriów oraz ogólnego samopoczucia. Co więcej, połączenie suplementacji z właściwie zbilansowaną dietą i metodami relaksacyjnymi stanowi kluczowy element skutecznej terapii mitochondrialnej. Tak zintegrowane działania przynoszą liczne korzyści, szczególnie w przypadku wielu schorzeń, w tym zaburzeń neurologicznych i chronicznego zmęczenia.

